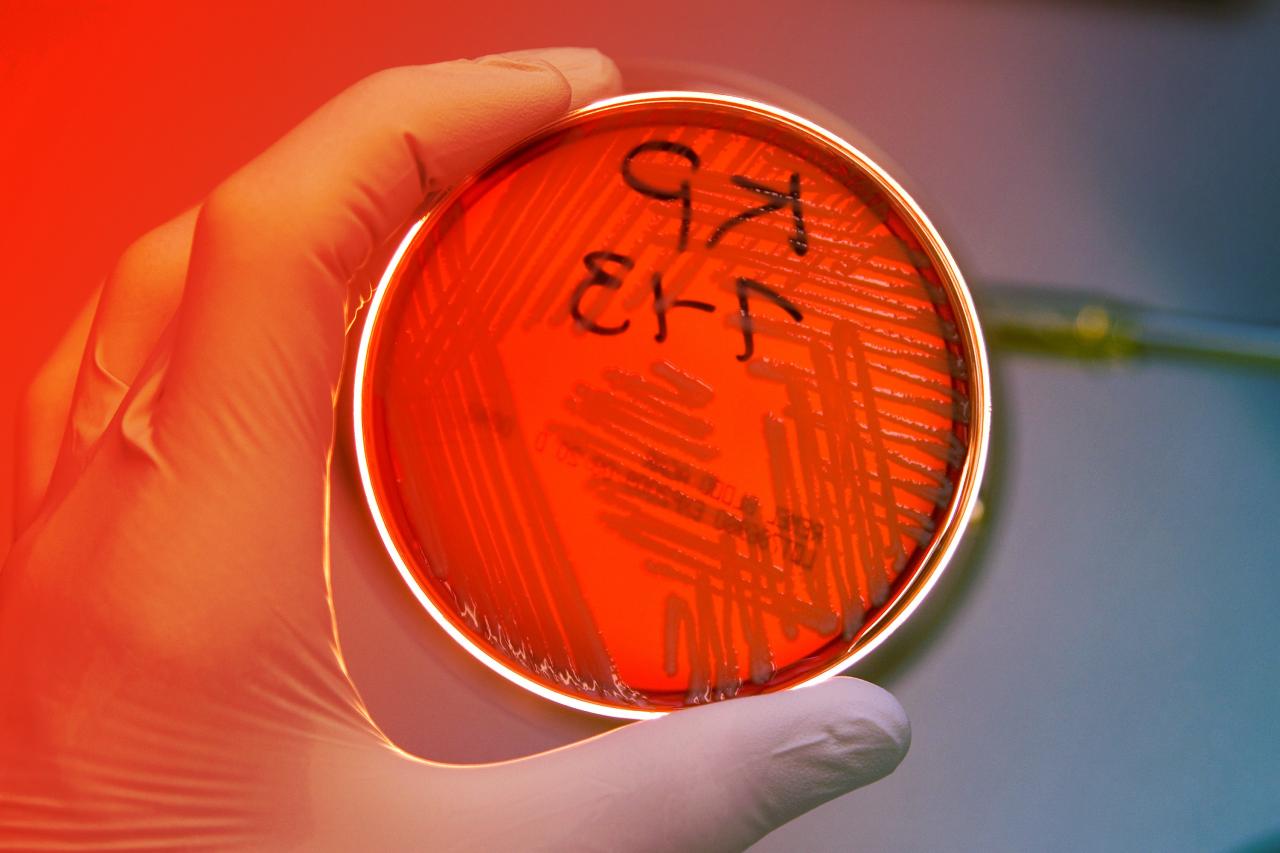
Újra támadnak a veszélyes éjszakai baktériumok a kórházakban

Az új mutáns: NDM-CRE
Az Enterobacterales több ismert baktériumot is magában foglal, köztük az E. coli-t és a Klebsiella pneumoniae-t. Ezek közül a legaggasztóbb a New Delhi metallo-béta-laktamáz (NDM) nevű gént hordozó változat, amelynek terjedése 461%-kal nőtt, és a kórházi ellátáson áteső betegek a legkiszolgáltatottabbak vele szemben. Ez a gén olyan enzimet termel, amely hatástalanítja a karbapenem antibiotikumokat. Az NDM-CRE a kórházi eszközökön, például lélegeztetőgépeken és infúziós csöveken keresztül villámgyorsan terjed. Mindezek ellenére az ilyen fertőzések egyelőre ritkák, és főként intézményi környezetben fordulnak elő, de a szakértők attól tartanak, hogy idővel a közösségekben is elterjedhetnek.
Komoly veszélyt jelent a közösségekre is
Az NDM-CRE ellen jelenleg csak intravénásan adható antibiotikumok hatnak, emiatt a szokványos, szájon át szedhető gyógyszerek lassan hatástalanokká válhatnak még a leggyakoribb fertőzésekkel szemben is. Ennek következményeként egyre több eset igényelhet kórházi kezelést és drága gyógyszereket: egy ilyen kezelés akár több millió forintba is kerülhet az Egyesült Államokban. Az NDM gén ráadásul más baktériumoknak is át tudja adni az ellenállóképességet, ami tovább súlyosbítja a helyzetet.
Mi áll a háttérben?
A CDC kutatói szerint a fertőzések terjedésében több tényező is szerepet játszik: az elégtelen kézfertőtlenítés, a hiányos eszköztisztítás, a kevés és nem elég gyors diagnosztika mind elősegítik a kórokozók terjedését. Ha a fertőzést későn ismerik fel, a célzott, életmentő kezelés is csak később kezdődhet meg, így könnyebben átterjedhet egyik betegtől a másikig.
Mire számíthatunk?
A gyógyszerrezisztens fertőzések hulláma nem csak az egészségügy számára jelent kihívást: ha ezek a kórokozók bekerülnek a társadalomba, egy egyszerű hólyaghurut (urinary tract infection) vagy tüdőgyulladás (pneumonia) is végzetessé válhat. A szakértők éppen ezért hangsúlyozzák: kiemelten fontos, hogy speciális, gyors laboratóriumi vizsgálatokkal időben kiszűrjék az ellenálló géneket, és az érintettek minél előbb megfelelő kezelést kapjanak.
